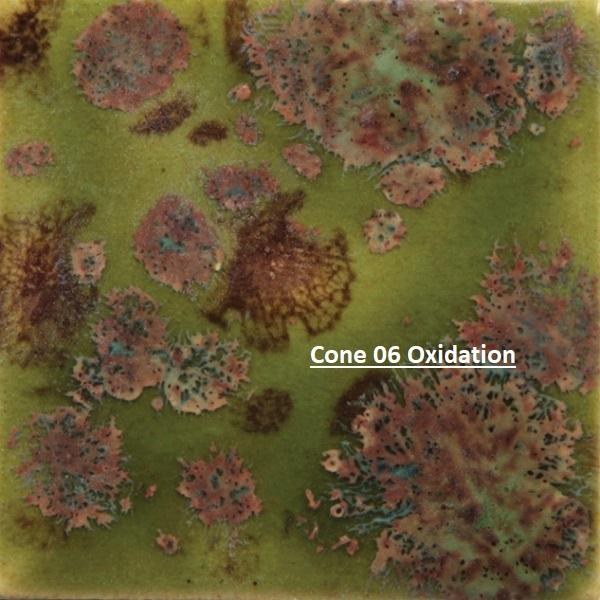

CG716 - Pagoda Green (CL) Crystal Glaze, Cone 06-10, 4oz
Item#: 4CG716
UPC: 097539334645
MPN: CG7164
*Image shown fired to Cone 06 Oxidation.
CONE 06 OXIDATION:
- Pagoda Green is a translucent green base glaze with variegated sage/brown crystals.
CONE 6 OXIDATION:
- Base glaze changes to brown – crystals fade and melt. Enhanced mobility. Surface issues may occur.
Mayco’s Jungle Gems™ Crystal Glazes transform in the kiln when the small pieces of glass frit burst into color and intricate patterns during the firing process. Artists use these beautiful glazes to add dramatic, colorful effects to their creations.
ART IN A JAR!™
Often cited as “Art in a Jar”, our Jungle Gems™ Crystal Glazes are easy to use while providing outstanding results.
FOR ARTISTS OF ALL AGES
Unleash your creativity with Mayco’s Jungle Gems™ Crystal Glazes. These stunning glazes allow ceramic artists to add color and depth to their designs with ease. Use alone for stunning effects, in glaze combination blending with Stroke & Coats®, Foundations® or Cobblestones or simply as an accent to your design.
* All Fired Examples Can Be Found On Mayco's Website under Projects.
Recommended Use:
** Jungle Gems™ Crystal Glazes are recommended for ornamental use only when applied to low fire earthenware clay bodies.
** All but eight Jungle Gems™ glazes have been certified as Non-Toxic, suitable for use by artists of all ages when used according to manufacturer’s directions.
** Jungle Gems™ are not recommended for dinnerware produced from low fire earthenware clay bodies as these glazes can exhibit surface textures such as cracks and crevices.
** While the glazed surface may pass lead &cadmium leach tests, and therefore legally considered Food Safe, attempts to adequately clean the textured surface may cause the underlying porous ware to absorb water and fail.
** Jungle Gems™ glazes may be considered dinnerware safe if surface texture is eliminated when firing to mid-range or high fire temperatures.
** We invite you to unleash your creativity with Jungle Gems™ Crystal Glazes.
Layering Crystals
To create unique effects and finishes, layer crystal together to create ombre effects or make an entirely new crystal color.

Glaze Combinations
Crystals add visual interest in designs and as a backdrop to your artwork. Design with glaze combinations by layering with Stroke & Coat®, Foundations® or Cobblestone.

Wide Firing Range
Jungle Gems™ glazes perform at mid-range (cone 5/6) temperatures for very interesting results. We recommend testing at your preferred firing temperature prior to use. Check label of specific color for performance at higher temperatures.

General Use
* Crystal glazes were designed to mature at cone 06/05. Shake the jar well and stir during the application process.
* Apply two to three even coats to shelf cone 04 bisque with a fan brush, allow to dry between coats.
* We recommend a soft fan brush, such as CB-604 #4 or CB-618 #8 Soft Fan, for glaze application.
* Stir frequently as crystals tend to settle in the jar due to their weight. Re-distribution of crystals may be requiredduring the final coat. Where you see the crystal is where you will see it bloom.
* Avoid heavy application of crystals at the bottom of ware as the crystals bloom and can adhere to the kiln shelves or stilts.
* The crystals in the glaze will melt when fired, which may create a textured surface.
* Jungle Gems™ Crystal Glazes have a natural crazing that occurs when the crystals “bloom”. As that surface may be difficult to properly clean if in contact with food,we recommend crystal glazes to be used on decorative ware.
* Jungle Gems™ Crystal Glazes have been formulated to mature at cone 06/05. However can be fired at higher temperatures. Their performance at cone 6 is noted on each individual product label. Crystals tend to flow at higher temperatures so take care on vertical pieces.
* We recommend testing on your clay body and in your kiln prior to use.
** Jungle Gems™ glazes are a mix of certified AP Non-Toxic and caution label CL. CG-707 Woodland Fantasy, CG-713 Peacock Green, CG-716 Pagoda Green, CG-717 Pistachio, CG-962 Blue Azure, CG-967 Green Agate, CG-979 Meadow, and CG-982 Mixed Melon require a caution label, CL, due to soluble copper and CG-973 Alligator due to barium. All other Jungle Gems™ are AP Non-Toxic.
** Jungle Gems™ Crystal Glazes are recommended for ornamental use only when applied to low-fire earthenware clay bodies. All but the above-mentioned Jungle Gems™ glazes have been certified as AP Non-Toxic, suitable for use by artists of all ages when used according to the manufacturer’s directions. Jungle Gems™ are not recommended for dinnerware produced from low-fire earthenware clay bodies as these glazes can exhibit surface textures such as cracks and crevices. While the glazed surface may pass lead & cadmium leach tests, and therefore legally considered Food Safe, attempts to adequately clean the textured surface may cause the underlying porous ware to absorb water and fail. Jungle Gems™ glazes may be considered dinnerware safe if surface texture is eliminated when firing to mid-range or high fire temperatures.
Helpful Hints
** Shake well prior to each application coat. The reason for this recommendation is that the crystals will settle to the bottom of the jar in a short period of time. If you notice the crystals settling during an application you can either dip your brush to the bottom of the jar to re-dispense or attach the lid and shake vigorously.
** During the application of the third coat of glaze, you may find it necessary to
re-distribute crystals or add crystals, on your piece to assure balanced coverage.
Use your brush to push crystals onto thinly covered areas or dip your
brush into the jar and gather crystals onto it, then “pat”
them on the sparsely covered areas.
** We recommend a broad, soft brush, such as a CB-604 #4 or CB-618 #8 Soft
Fan Brush, to apply crystal glazes. The fan brush may help more in the even
disbursement of the crystals, thus creating a more pleasing pattern
in the fired glaze.
** When using Jungle Gems™ on the outside of a vase or cylinder, we
recommend using Foundations® opaque, Foundations® sheer, or a clear
glaze on the inside. Using Stroke & Coat™ may cause the piece to crack
due to the stiffness of the glaze.
** Jungle Gems™ were designed to fire to cone 06. Higher temperature firings
will change the colors from cone 06 results and movement
and flow WILL increase.
What are some of the ways I can use Jungle Gems™ crystal glazes in my design work?
Simply apply the crystals in the pattern and apply as the above directions stated. Several rings of the crystals placed in varied patterns are also attractive. Interesting patterns may be obtained by placing several rings of crystals in a necklace-like placement around the piece. The glaze may need to be strained in order to separate the crystals for this procedure. The crystals are then applied using a brush or small spoon in a linear necklace-like ring around the piece. This can be several rings in sequential order or in a zigzag pattern to produce the most pleasing effect.
Can I mix leftover crystals into other glazes?
Yes. Foundations® Sheers and Opaques would be a good choice as these glazes will allow the crystals to expand much like the base glaze of Jungle Gems™.
Are Jungle Gems the same as Crystalite glazes?
Jungle Gems™ crystal Glazes have been in the market for many years and were originally formulated using a leaded frit. In 2005, they were converted to a leadless formula, similar to the Mayco Crystalites glaze, which have always been lead-free. We have merged these two great product lines into one, all under the Jungle Gems™ brand. This merge simplifies the selection for the consumer as the glazes perform identically. Crystalite colors will keep their item numbers, name and the entire Crystal Glaze product line remains lead-free.
Can I mix Crystal glazes together?
Yes, you may mix and create an entirely new crystal color that is pleasing. Mayco recommends testing first as it is unpredictable results.
Instruction say may have surface characteristics (crazing). Can I add a coat of clear glaze over the top to fix the issue?
No, for one thing clear glaze may change the color of the crystal glaze. And two, it does not prevent the natural crazing when the crystals “bloom”.
Can I use Jungle Gem™ Crystals Glazes on utility or dinnerware pieces?
Jungle Gems™ crystal Glazes are recommended for ornamental use only when applied to low fire earthenware clay bodies. All but three Jungle Gems™ glazes have been certified as Non-Toxic, suitable for use by artists of all ages when used according to manufacturer’s directions. Jungle Gems™ are not recommended for dinnerware produced from low fire earthenware clay bodies as these glazes can exhibit surface textures such as cracks and crevices. While the glazed surface may pass lead & cadmium leach tests, and therefore legally considered Food Safe, attempts to adequately clean the textured surface may cause the underlying porous ware to absorb water and fail. Jungle Gems™ glazes may be considered dinnerware safe if surface texture is eliminated when firing to mid-range or high fire temperatures.
What advice to do have for firing Crystal glazes to mid-range temperatures?
Jungle Gems™, already prone to move, will move that much more at mid-range temperatures. The crystals will lose some of their definition and act more as a blending agent. You’ll want to be careful about placing glaze too close to the bottom of your piece – in addition to stilting you may want to put a tile or a piece of scrap bisque beneath the piece to prevent glaze from running onto your kiln shelves.

Share:
Share on Facebook Share on Twitter Share on Pinterest Tell a friend